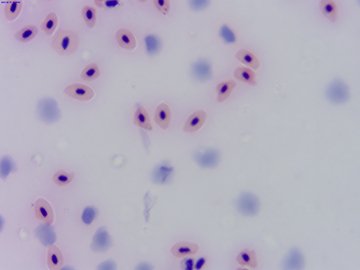

產品名稱: 數碼采集裝置LV1800
產品類型: 臨時分類
產品型號: 數碼采集裝置LV1800
發布時間: 2020-09-17
- 數碼采集裝置LV1800產品描述
數碼采集裝置LV1800相機我們設計的一種超高性能USB3.0CMOS相機帶硬件ISP超精細顏色引擎(HardwareISPandVideoPipelineUSB3.0CMOS相機),采用USB3.0作為數據傳輸接口。
LV1800相機分辨率1800萬,圖像傳輸速度更快;
LV1800相機隨機提供高級視頻與圖像處理應用軟件,并提供Windows/Linux/OSX多平臺SDK;支持原生C/C++,C#/VB.NET,Directshow,TwainAPI;
U3ISPM系列相機可以廣泛用于顯微圖像的拍攝與記錄。

產品型號:LV1800
芯片型號:索尼IMX183
芯片大小:18M/AR1820(C)
1/2.3"(6.14x4.61)
像素大小:1.25x1.25
最大分辨率:1800萬像素
幀速:13.1@4912x3684"
34.3@2456x1842
54.4@1228x922
曝光時間:0.1ms~2s
G光靈敏度:0.62V/lux-sec65.8Db36.3d
- 其他產品